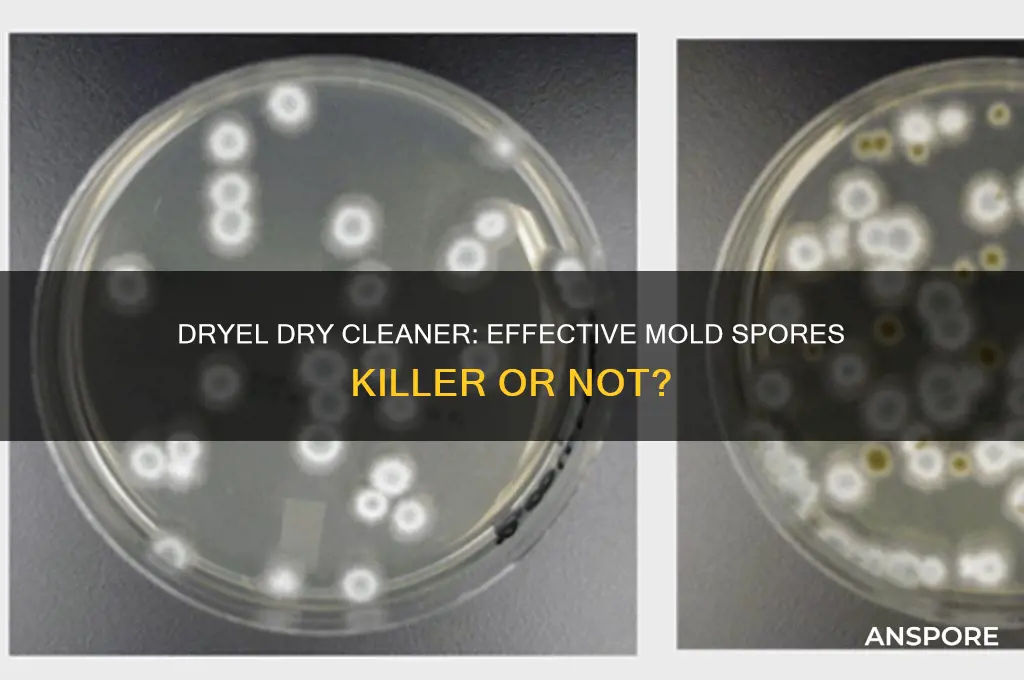
does dryel dry cleaner kill mold spores

Dryel dry cleaner is a popular at-home dry cleaning kit that uses a patented fabric protector bag and a cleaning cloth to refresh and remove odors from clothing. However, when it comes to the question of whether Dryel can kill mold spores, the answer is not straightforward. Mold spores are microscopic organisms that thrive in damp environments and can cause health issues if left untreated. While Dryel is effective at removing odors and refreshing fabrics, it is not specifically designed to target or eliminate mold spores. Traditional dry cleaning methods, which use harsh chemicals and high heat, are more likely to kill mold spores, but Dryel's gentle cleaning process may not be sufficient to eradicate these resilient organisms. Therefore, if you suspect mold growth on your clothing, it is advisable to consult a professional cleaner or use specialized mold remediation products to ensure complete removal.
| Characteristics | Values |
|---|---|
| Effectiveness on Mold Spores | Dryel Dry Cleaner is not specifically designed to kill mold spores. It is primarily intended for at-home dry cleaning of garments and fabrics. |
| Active Ingredients | Contains a cleaning cloth with a stain-removing solution and a drying bag. The solution typically includes surfactants and solvents but lacks antimicrobial agents effective against mold. |
| Heat Component | The process involves using a dryer’s heat, which may reduce some mold spores but is not guaranteed to kill all spores effectively. |
| Recommended Use | Best for refreshing and cleaning fabrics, not for mold remediation or disinfection. |
| Safety | Safe for most fabrics but not a substitute for professional mold treatment or antimicrobial products. |
| Limitations | Does not replace professional mold removal methods or specialized mold-killing products. |
| Alternative Solutions | For mold, use EPA-registered fungicides or consult professional mold remediation services. |
Explore related products
$13.48 $14.13
What You'll Learn

Dryel's effectiveness against mold spores
Dryel, a popular at-home dry cleaning kit, is often touted for its convenience in refreshing garments without the need for professional dry cleaning. However, its effectiveness against mold spores is a specific concern that requires careful examination. Mold spores are resilient microorganisms that thrive in damp, dark environments, and eliminating them from fabrics can be challenging. While Dryel is designed to remove odors and refresh clothing, its active ingredients—primarily a cleaning cloth containing surfactants and a drying bag with a moisture-absorbing agent—are not specifically formulated to target mold spores. This raises questions about whether Dryel can effectively neutralize these harmful particles.
To assess Dryel’s potential against mold spores, it’s essential to understand its mechanism. The cleaning cloth works by lifting dirt and odors from fabrics, while the drying bag helps reduce moisture, a key factor in mold growth. However, mold spores require more than just moisture removal to be eradicated; they need exposure to antimicrobial agents or high heat. Dryel’s instructions do not include a heat-intensive step, as it relies on a low-heat dryer cycle, which may not reach the temperatures necessary to kill mold spores (typically above 140°F or 60°C). Additionally, the surfactants in the cleaning cloth are not known for their antimicrobial properties, leaving a gap in Dryel’s ability to combat mold at its source.
For those dealing with mold-contaminated garments, relying solely on Dryel could be insufficient. Instead, a multi-step approach is recommended. First, brush off visible mold spores outdoors to prevent further spread. Then, pre-treat the fabric with a mold-killing solution, such as a mixture of water and vinegar or a commercial antimicrobial spray. After treatment, washing the garment in hot water (if fabric-safe) is crucial to eliminate remaining spores. Only then can Dryel be used as a secondary step to refresh the fabric and remove any residual odors. This layered approach ensures that mold spores are not just masked but effectively neutralized.
Comparatively, professional dry cleaning methods often include high-heat drying and chemical treatments that are more effective against mold spores. Dryel’s convenience comes at the cost of specialized mold remediation capabilities. For lightly soiled or odor-affected garments, Dryel may suffice, but for mold-infested items, it should be part of a broader strategy rather than a standalone solution. Always inspect garments post-treatment to ensure mold has been fully eradicated, as lingering spores can pose health risks and cause recurrence.
In conclusion, while Dryel is a handy tool for refreshing fabrics, its effectiveness against mold spores is limited. Its lack of antimicrobial agents and reliance on low-heat drying make it inadequate for mold remediation on its own. For best results, combine Dryel with proven mold-killing techniques, such as hot water washing and antimicrobial treatments. This ensures both the cleanliness and safety of your garments, addressing mold at its root rather than merely masking the problem.
Can Cooking Effectively Kill Spores in Food? Facts and Myths
You may want to see also

Ingredients in Dryel that target mold
Dryel's effectiveness against mold spores hinges on its active ingredients, which work synergistically to eliminate both visible mold and its airborne spores. The primary component, sodium carbonate, acts as a natural deodorizer and mild disinfectant. When heated during the drying cycle, it creates an alkaline environment that disrupts mold cell walls, rendering spores inactive. This process is particularly effective for fabrics that cannot withstand harsh chemical treatments, making Dryel a gentler alternative to traditional dry cleaning methods.
Another key ingredient, sodium percarbonate, releases oxygen when activated by heat, creating a bubbling action that lifts mold spores from fabric fibers. This oxygenation process not only kills mold but also breaks down the organic matter it feeds on, preventing regrowth. For optimal results, ensure the dryer reaches a temperature of at least 140°F (60°C), as lower temperatures may not fully activate the sodium percarbonate. This step is crucial for fabrics like wool or silk, which are prone to mold but sensitive to high heat.
While Dryel’s ingredients target mold effectively, their success depends on proper usage. Overloading the dryer can prevent adequate heat distribution, reducing the product’s efficacy. Conversely, using too little Dryel may not provide sufficient active ingredients to combat mold. Follow the package instructions carefully, typically using one Dryel sheet per load for light mold issues and two sheets for heavier infestations. For persistent mold problems, consider pre-treating fabrics with a mold-specific spray before using Dryel.
It’s important to note that Dryel is not a substitute for professional mold remediation in severe cases. While its ingredients can kill mold spores on fabrics, they do not address underlying moisture issues or mold growth on hard surfaces. For comprehensive mold control, combine Dryel with dehumidifiers, proper ventilation, and regular cleaning of mold-prone areas. This dual approach ensures both fabrics and living spaces remain mold-free.
Finally, Dryel’s mold-fighting ingredients are safe for most fabrics, but always check garment care labels before use. Delicate items like lace or heavily embellished clothing may require hand washing or professional cleaning. For households with children or pets, Dryel’s non-toxic formula offers peace of mind, though it’s still advisable to store the product out of reach. By understanding and leveraging its active ingredients, Dryel becomes a practical tool in the fight against mold, particularly for fabric care.
Oxone's Power: Can It Effectively Eliminate Mold Spores?
You may want to see also

Temperature role in mold spore removal
Heat is a mold spore's nemesis, and understanding its role in eradication is crucial for effective cleaning. Mold spores are remarkably resilient, capable of surviving in dormant states for years, waiting for the right conditions to reactivate and proliferate. However, research shows that exposing these spores to temperatures above 140°F (60°C) for at least 30 minutes can effectively kill them. This principle is leveraged in various cleaning methods, including dry cleaning, where heat plays a pivotal role in sanitization. For instance, the Dryel dry cleaning system, which uses a dryer's heat to refresh clothes, can potentially kill mold spores if the dryer reaches and maintains the necessary temperature threshold.
In practice, achieving and maintaining the required temperature is not as straightforward as it seems. Home dryers often vary in their ability to reach and sustain 140°F, especially with full loads or energy-efficient models designed to minimize heat output. To maximize effectiveness, ensure your dryer is set to its highest heat setting and avoid overloading it, as this can prevent adequate heat distribution. Additionally, preheating the dryer for a few minutes before adding the items can help ensure the internal temperature is sufficiently high. For those with mold-sensitive individuals in the household, investing in a dryer with a sanitize cycle, which is specifically designed to reach and maintain higher temperatures, might be a worthwhile consideration.
While heat is a powerful tool against mold spores, it’s not a standalone solution. Combining heat treatment with other mold remediation techniques, such as HEPA vacuuming and the use of antifungal agents, can provide a more comprehensive approach. For example, after heat treatment, wiping surfaces with a solution of water and vinegar can help remove any remaining mold residue and inhibit future growth. It’s also essential to address the root cause of mold, such as moisture issues, to prevent recurrence. Proper ventilation, dehumidification, and prompt repair of leaks are critical steps in maintaining a mold-free environment.
Comparing heat treatment to other mold removal methods highlights its efficiency and eco-friendliness. Unlike chemical treatments, which may leave residues or pose health risks, heat treatment is non-toxic and leaves no harmful byproducts. It’s also more thorough than surface cleaning, as heat can penetrate fabrics and materials where mold spores might hide. However, heat treatment is not suitable for all materials, particularly those that are heat-sensitive, such as certain plastics, silks, or delicate electronics. Always check the care label or manufacturer’s instructions before applying heat to avoid damage.
In conclusion, temperature plays a critical role in mold spore removal, with heat above 140°F being particularly effective. By understanding how to harness this power, whether through home dryers or specialized equipment, individuals can enhance their mold remediation efforts. However, it’s important to combine heat treatment with other strategies and to be mindful of material compatibility. With the right approach, heat can be a safe, efficient, and environmentally friendly tool in the fight against mold.
Can Vinegar Kill Tetanus Spores? Debunking Myths and Facts
You may want to see also
Explore related products
$25.95 $33.98

Dryel vs. traditional dry cleaning for mold
Mold spores are a persistent problem, especially in damp environments, and their presence on clothing can be a health hazard. When it comes to removing mold from garments, the choice between Dryel and traditional dry cleaning methods is crucial. Dryel, a home dry cleaning kit, uses a patented fabric protector bag and a cleaning cloth infused with a stain-fighting solution, which is then heated in a dryer to refresh and clean clothes. Traditional dry cleaning, on the other hand, involves professional cleaning using chemical solvents like perchloroethylene (perc) to dissolve oils and stains.
Effectiveness Against Mold Spores
Dryel’s process relies on heat and steam generated in a standard dryer, which can help reduce mold spores by exposing them to high temperatures. However, Dryel is not specifically designed to kill mold spores, and its effectiveness is limited to surface-level cleaning. Mold spores require sustained heat (above 140°F or 60°C) for at least 10 minutes to be effectively neutralized. While a dryer can reach these temperatures, Dryel’s instructions do not guarantee this duration, leaving room for uncertainty. Traditional dry cleaning, particularly when combined with professional-grade steam or heat treatments, can more reliably target mold spores due to the controlled environment and higher temperatures used in industrial dryers.
Practical Considerations
For minor mold issues on durable fabrics, Dryel can be a convenient and cost-effective solution. It’s ideal for quick touch-ups and refreshing items that aren’t heavily soiled. However, for severe mold infestations or delicate fabrics, traditional dry cleaning is the safer bet. Professionals can assess the fabric type, apply appropriate treatments, and ensure thorough cleaning without damaging the garment. Additionally, traditional dry cleaners often use fungicidal agents or specialized processes to address mold directly, which Dryel lacks.
Health and Environmental Impact
Dryel is a more eco-friendly option compared to traditional dry cleaning, as it avoids the use of harsh chemicals like perc, which can be harmful to both health and the environment. However, if mold spores are not fully eradicated, they can pose respiratory risks, especially for individuals with allergies or asthma. Traditional dry cleaning, while effective, relies on solvents that may leave chemical residues and contribute to air pollution. For those prioritizing health, it’s essential to weigh the risks of mold exposure against the potential hazards of chemical solvents.
Step-by-Step Guidance
If using Dryel for mold, follow these steps: pre-treat visible mold with a mixture of water and vinegar, place the garment in the Dryel bag, and run the dryer on high heat for at least 30 minutes. For traditional dry cleaning, clearly communicate the mold issue to the cleaner, who may use steam treatments or fungicides to ensure thorough removal. Always inspect garments post-cleaning to confirm mold has been eliminated. In severe cases, consider discarding the item to prevent spore spread.
In summary, while Dryel offers convenience and eco-friendliness, traditional dry cleaning provides a more reliable solution for mold removal, especially in severe cases. The choice depends on the extent of the mold issue, fabric type, and personal priorities regarding health and environmental impact.
Can Haloid Cells Undergo Meiosis to Form Spores?
You may want to see also

Preventing mold recurrence with Dryel use
Dryel, a home dry cleaning kit, is often touted for its convenience and effectiveness in refreshing garments. However, its role in preventing mold recurrence is less discussed but equally important, especially in humid environments where mold thrives. Mold spores are resilient and can survive on fabrics, making it crucial to address them during the cleaning process. Dryel’s heat-activated cleaning cloth, when used in a dryer, generates warmth that can help eliminate mold spores by disrupting their cellular structure. This method is particularly useful for delicate items that cannot withstand traditional washing or chemical treatments.
To maximize Dryel’s mold-preventing potential, follow these steps: first, inspect garments for visible mold and pre-treat affected areas with a mild detergent or vinegar solution. Next, place the item in the Dryel bag with the provided cleaning cloth, ensuring it is not overcrowded. Run the dryer on medium heat for 15–20 minutes, as higher temperatures can damage delicate fabrics but are necessary to kill spores. After the cycle, air-dry the garment in a well-ventilated area to prevent moisture buildup, which can encourage new mold growth. Repeat this process for items stored in damp environments or prone to mold exposure.
While Dryel’s heat-based approach is effective, it is not a standalone solution for mold prevention. Pair its use with environmental controls, such as maintaining indoor humidity below 50% and ensuring proper ventilation in closets and storage areas. For heavily infested items, consider professional cleaning or discarding them to avoid cross-contamination. Dryel’s convenience makes it an accessible tool for regular maintenance, but it should complement, not replace, broader mold prevention strategies.
Comparatively, Dryel offers a gentler alternative to harsh chemical treatments, which can degrade fabrics over time. Its heat-activated method is safe for most delicate materials, including wool and silk, making it ideal for preserving garments while addressing mold concerns. However, it is less effective on porous materials like upholstery, where mold can penetrate deeply. In such cases, combine Dryel use with steam cleaning or professional intervention for comprehensive results.
In conclusion, Dryel’s ability to prevent mold recurrence lies in its heat-activated process, which targets spores without damaging fabrics. By integrating it into a routine care regimen and addressing environmental factors, users can protect their garments effectively. While not a cure-all, Dryel is a valuable tool in the fight against mold, particularly for delicate items that require gentle handling. Practicality and consistency are key to leveraging its benefits fully.
Can Fungal Spores Survive Freezing Temperatures? Exploring Their Resilience
You may want to see also
Frequently asked questions
Dryel is designed for at-home dry cleaning and does not specifically target or kill mold spores. It is primarily for removing stains and refreshing fabrics.
Dryel is not effective for removing mold from clothing. Mold requires specialized cleaning methods, such as washing with hot water and mold-killing detergents or professional treatment.
While Dryel uses heat during its drying cycle, it may not reach temperatures high enough to reliably kill mold spores. Mold spores are resilient and require sustained high heat or specific treatments to be eliminated.
Using Dryel on moldy fabrics is not recommended, as it does not address the mold issue and may spread spores to other items in the dryer bag.
For moldy clothing, wash the items in hot water with a mold-killing detergent or vinegar, and consider professional cleaning for severe cases. Avoid using Dryel for mold removal.

























